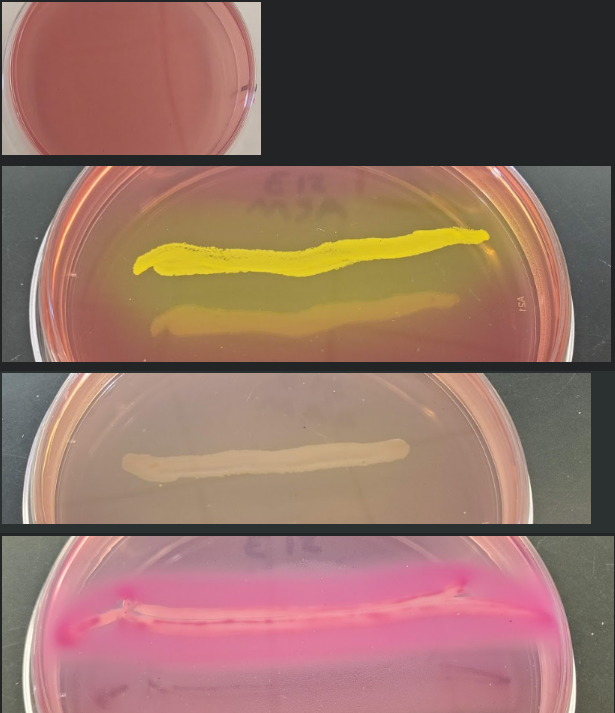
<p><span>You have a patient with intestinal distress, who has eaten eggs contaminated with </span><em>Salmonella enterica. </em><span>You request a stool sample.&nbsp; </span><em>Salmonella </em><span>is a Gram-negative rod that does not ferment lactose or mannitol.&nbsp; It is not a halophile.&nbsp; It is not hemolytic. What would you observe if you plated this sample on a MAC plate?</span></p>
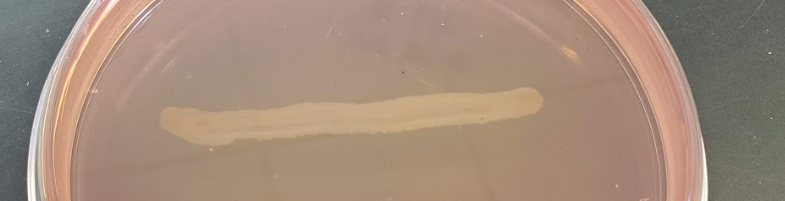
knowt flashcard image
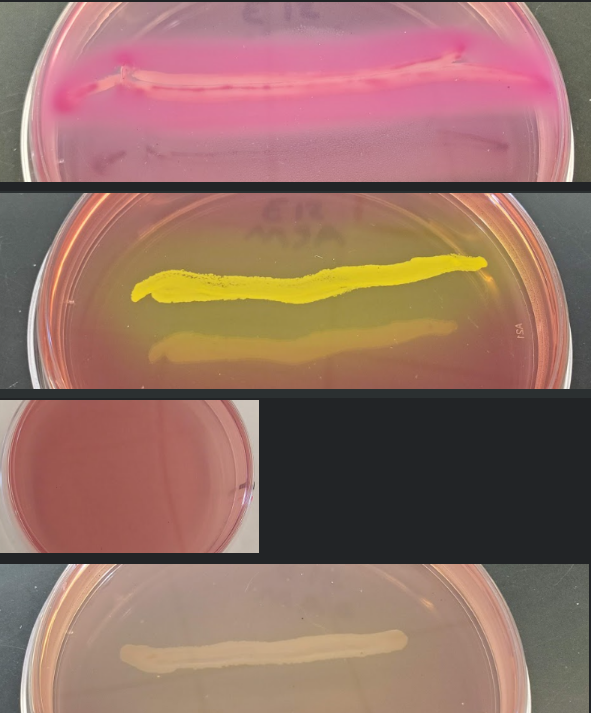
<p><span>You have a patient with a boil on their skin. &nbsp;You suspect </span><em>Staphylococcus aureus.</em><span>&nbsp; </span><em>S. aureus </em><span>is a Gram-positive cocci that ferments mannitol. It is capable of beta-hemolysis.&nbsp; It is a halophile.&nbsp; It does not ferment lactose.&nbsp; What would you observe if you plated this sample on a MSA plate?</span></p>
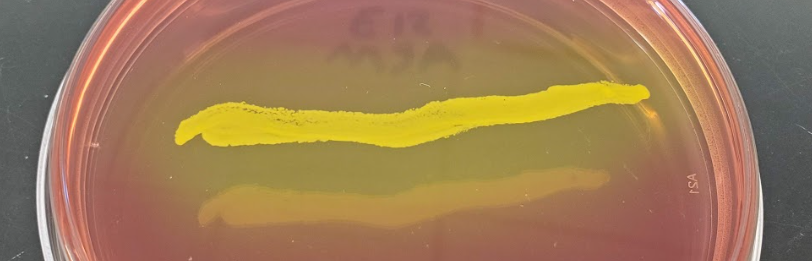
knowt flashcard image

Microbio Exam 3 Postlabs 11-17 Images
1/11
There's no tags or description
Looks like no tags are added yet.
Name | Mastery | Learn | Test | Matching | Spaced | Call with Kai |
|---|
No analytics yet
Send a link to your students to track their progress
12 Terms
You have a patient with intestinal distress, who has eaten eggs contaminated with Salmonella enterica. You request a stool sample. Salmonella is a Gram-negative rod that does not ferment lactose or mannitol. It is not a halophile. It is not hemolytic. What would you observe if you plated this sample on a MAC plate?

You have a patient with a boil on their skin. You suspect Staphylococcus aureus. S. aureus is a Gram-positive cocci that ferments mannitol. It is capable of beta-hemolysis. It is a halophile. It does not ferment lactose. What would you observe if you plated this sample on a MSA plate?

You have a patient with a sore throat. You suspect Streptococcus pyogenes. S. pyogenes is a Gram-positive cocci that is beta hemolytic. It is not a halophile. It does not ferment lactose or mannitol. What would you observe if you plated this sample on a SBA plate?


Each of the tubes below was inoculated with bacteria. Following 24 hours of incubation, methyl red was added. Which tube contains bacteria that produce neutral products following sugar metabolism?


Which bacteria are motile? (Select all that apply.)


Which tube was inoculated with bacteria that can break down tryptophan?


Which bacteria reduce Sulfur? (Select all that apply.)


If bacteria A can utilize citrate as a carbon source then it will what color?


Question options:
This bacteria produces the enzyme urease that degrades urea.
This bacteria ferments the sugar urea.
This bacteria does not ferment the sugar urea.
This bacteria does not produce the enzyme urease that degrades urea.
This bacteria produces the enzyme urease that degrades urea.

Question options:
This bacteria ferments the carbohydrate lactose (included in the broth) and produces Carbon Dioxide gas, but does not produce acid.
This bacteria ferments the carbohydrate lactose (included in the broth) and produces lactic acid and Carbon Dioxide gas.
This bacteria ferments the carbohydrate lactose (included in the broth) and produces lactic acid and Oxygen gas.
This bacteria does not ferment the carbohydrate lactose (included in the broth.)
This bacteria ferments the carbohydrate lactose (included in the broth) and produces lactic acid but does not produce gas.
This bacteria ferments the carbohydrate lactose (included in the broth) and produces lactic acid and Carbon Dioxide gas.

If you have identified a Gram positive staphylococci that is positive in the catalase test, you will perform a coagulase test. Which of the following is a positive coagulase test?


You have identified a Gram positive streptoococci that is negative for catalase production, has a clear halo of hemolysis when grown on the SBA, and does not have a zone of inhibition around the Bacitracin disc when tested for susceptibility. What should the CAMP test look like to confirm that you have Streptococcus agalactiae according to the Dichotemous Key for the Identification of Gram positive bacteria (found in the Experiment PPT?)
